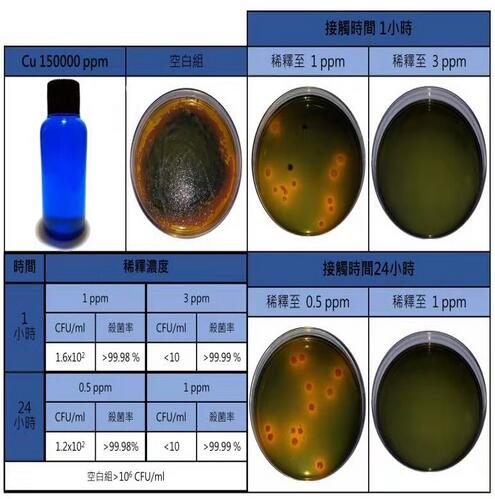
纳米铜溶液

网站主页
超高浓度纳米铜纯水溶液
纳米铜溶液
纳米铜溶液
Nano-copper solution
询价
25Kg/Drum
起订
江苏 更新日期:2026-04-17
产品详情:
- 中文名称:
- 纳米铜溶液
- 英文名称:
- Nano-copper solution
- 纯度规格:
- 99%
- 产品类别:
- 饲料添加剂
公司简介
南京百慕达生物科技有限公司(湖北鸿福达生物科技有限公司)成立于2019年,位于六朝古都金陵(江苏省南京市),公司产品包括化工中间体、医药中间体,染料中间体,精细化工、植物提取物等等,公司主营产品:L-丙交酯CAS:4511-42-6/3,4-二羟基二苯甲酮(10425-11-3)/卡培他滨、氟铁龙等抗癌药物中间体/1,2,3-三乙酰氧基-5-脱氧-D-核糖,CAS:62211-93-2/α-甲基葡萄糖甙 97-30-3/磷酸肌酸钠 922-32-7/ 6,11-二氢二苯并[b,e]氧杂卓-11-酮 4504-87-4/4-氯苯甲酰氨基丙二酸二乙酯 81918-01-6/2-(氯磺酰基)-3-甲基苯甲酸甲酯;3-甲基-2-磺酰氯苯甲酸甲酯 126535-26-0/(1S)-1-(2R)-环氧乙基-2-苯乙基氨基甲酸叔丁酯98760-08-8/邻苯二甲醛(OPA)|二硫氰基甲烷|2-硫脲嘧啶
| 成立日期 | (7年) |
| 注册资本 | 1000000 |
| 员工人数 | 1-10人 |
| 年营业额 | ¥ 100万以内 |
| 经营模式 | 贸易,工厂,试剂,定制,服务 |
| 主营行业 | 医药中间体,合成材料中间体,农药中间体,染料中间体,香精和香料中间体 |
纳米铜溶液相关厂家报价
-

- 超高浓度纳米铜纯水溶液
- 武汉熠嘉生物科技有限公司
- 2020-11-24
- 询价
-

- 纳米铜溶液
- 武汉熠嘉生物科技有限公司
- 2020-11-24
- 询价
-

- 纳米铜溶液
- 武汉熠嘉生物科技有限公司
- 2020-11-24
- 询价